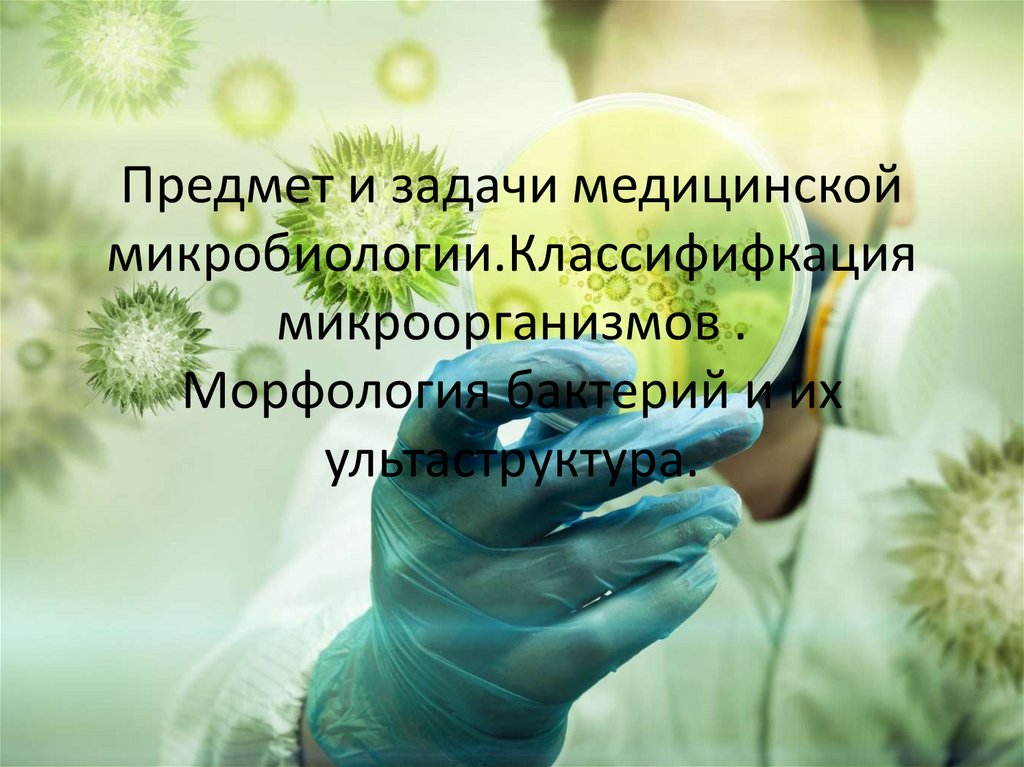
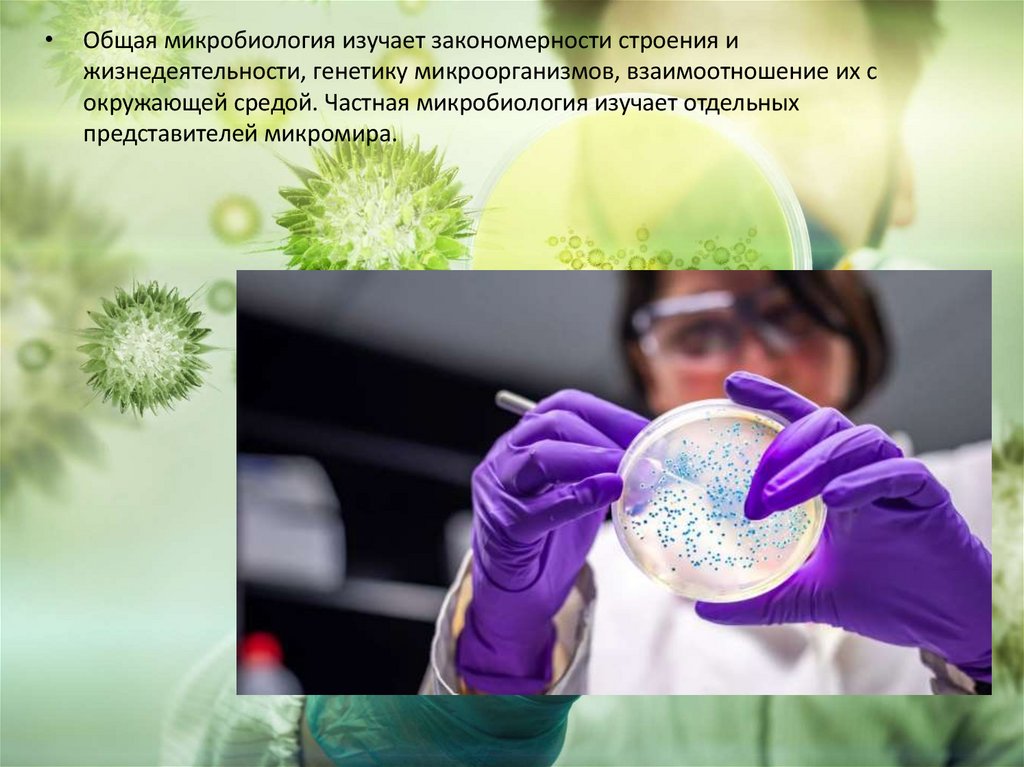
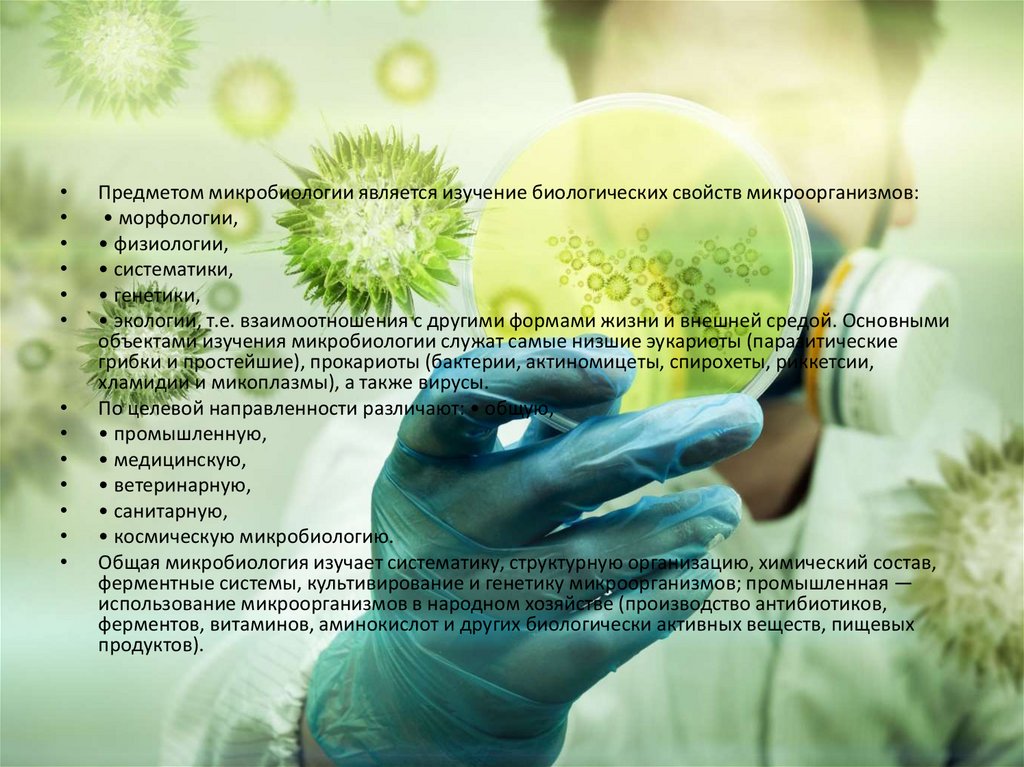
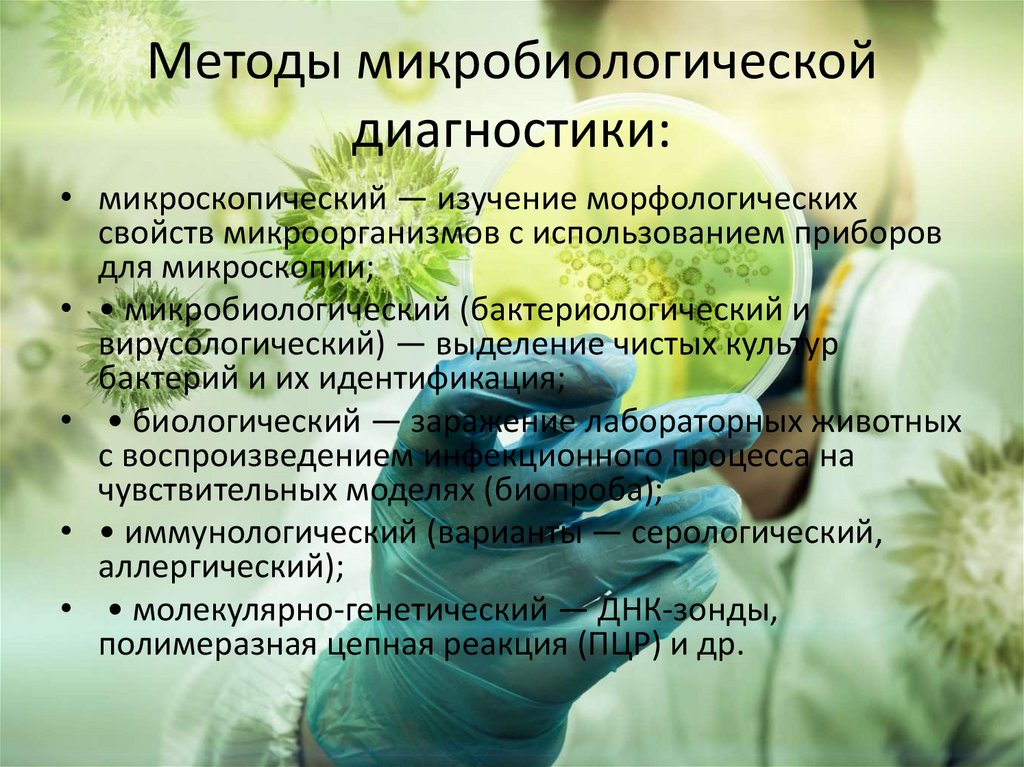
Методы микробиологической диагностики:
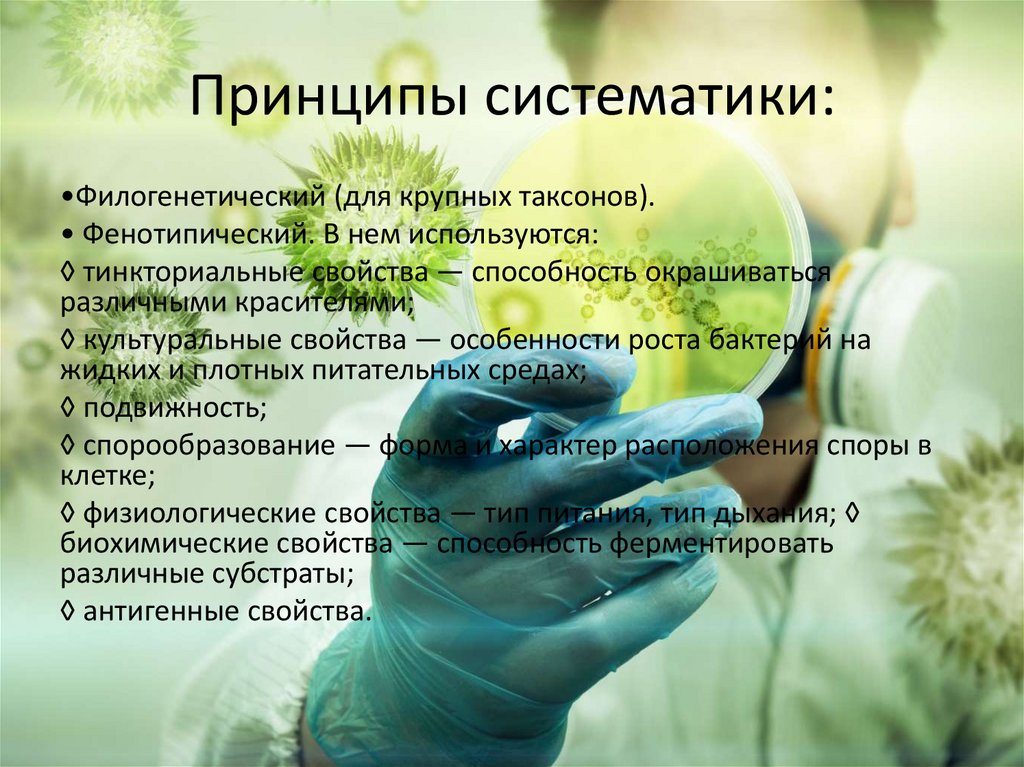
Принципы систематики:

Похожие презентации:
Предмет и задачи медицинской микробиологии. Классификация микроорганизмов . Морфология бактерий и их ультраструктура
1. Предмет и задачи медицинской микробиологии.Классифифкация микроорганизмов . Морфология бактерий и их ультаструктура.
2. Микробиология
• Микробиология (от micros — малый, bios — жизнь, logos — учение) —наука, изучающая закономерности жизни и развития мельчайших организмов
— микроорганизмов в их единстве со средой обитания, их биологические
признаки, систематика, экология, взаимоотношения с другими организмами.
3.
Общая микробиология изучает закономерности строения и
жизнедеятельности, генетику микроорганизмов, взаимоотношение их с
окружающей средой. Частная микробиология изучает отдельных
представителей микромира.
4.
Предметом микробиологии является изучение биологических свойств микроорганизмов:
• морфологии,
• физиологии,
• систематики,
• генетики,
• экологии, т.е. взаимоотношения с другими формами жизни и внешней средой. Основными
объектами изучения микробиологии служат самые низшие эукариоты (паразитические
грибки и простейшие), прокариоты (бактерии, актиномицеты, спирохеты, риккетсии,
хламидии и микоплазмы), а также вирусы.
По целевой направленности различают: • общую,
• промышленную,
• медицинскую,
• ветеринарную,
• санитарную,
• космическую микробиологию.
Общая микробиология изучает систематику, структурную организацию, химический состав,
ферментные системы, культивирование и генетику микроорганизмов; промышленная ―
использование микроорганизмов в народном хозяйстве (производство антибиотиков,
ферментов, витаминов, аминокислот и других биологически активных веществ, пищевых
продуктов).
5. Медицинская микробиология:
• - изучает морфологию, физиологию, экологиюи генетические характеристики нормальной
микрофлоры и возбудителей основных
инфекционных болезней человека;
• - осуществляет методы лабораторной
диагностики инфекционных заболеваний и
микробоносительства;
• - разрабатывает методы специфической
профилактики и лечения инфекционных
заболеваний.
6. Задачи медицинской микробиологии:
•установление роли микроорганизмов в норме и припатологии;
• разработка методов диагностики, специфической
профилактики и лечения инфекционных заболеваний;
• индикация (выявление) и идентификация (определение)
возбудителей инфекционных заболеваний;
• бактериологический и вирусологический контроль
окружающей среды, продуктов питания, режимов
стерилизации и др.;
• контроль за чувствительностью микроорганизмов к
антибиотикам и другим лечебным препаратам;
• контроль за состоянием микробиоценозов
(микрофлорой) поверхностей и полостей тела человека.
7. Методы микробиологической диагностики:
• микроскопический ― изучение морфологическихсвойств микроорганизмов с использованием приборов
для микроскопии;
• • микробиологический (бактериологический и
вирусологический) ― выделение чистых культур
бактерий и их идентификация;
• • биологический ― заражение лабораторных животных
с воспроизведением инфекционного процесса на
чувствительных моделях (биопроба);
• • иммунологический (варианты ― серологический,
аллергический);
• • молекулярно-генетический ― ДНК-зонды,
полимеразная цепная реакция (ПЦР) и др.
8. ЭТАПЫ РАЗВИТИЯ МИКРОБИОЛОГИИ
• Микробиология зародилась задолго до нашей эры ипрошла длительный путь развития, исчисляющийся
многими тысячелетиями. Историю развития
микробиологии можно разделить на 5 этапов.
• 1. Эмпирический (описательный) период — 6–5 тыс. л.
до н. э. – XVI в. н. э. Человек пользовался плодами
деятельности микроорганизмов (виноделие,
хлебопечение, сыроделие, выделка кож), не зная об их
существовании.(Дж. Фракасторо)
• 2. Морфологический период — конец XVII – середина
XIX в.: открытие мира микроорганизмов, описание их
внешнего вида, опыты по самозаражению с целью
доказать инфекционную природу многих
заболеваний(― А. Левенгук).
9.
• 3. Физиологический (пастеровский) период — конец XVIII –начало ХХ вв. Начало научной микробиологии: открыто
большинство возбудителей инфекционных заболеваний,
вирусы, разработана микробная концепция болезней, изучена
жизнедеятельность микробной клетки.
• 4. Иммунологический — начало – середина ХХ в. ―( И.И.
Мечников, П. Эрлих)
• 5. Молекулярно-генетический (современный) — с середины ХХ
в.: широкое использование молекулярных методов
исследования. Этому способствовали важнейшие открытия в
области молекулярной биологии и генетики.
10. Систематика, номенклатура, классификация микроорганизмов.
• Систематика занимается всесторонним описаниемвидов организмов, выяснением степени
родственных отношений между ними и
объединением их в различные по уровню родства
классификационные единицы (таксоны).
• Классификация — составная часть систематики.
Занимается распределением организмов в
соответствии с их общими признаками по
различным таксонам.
• Таксономия — наука о принципах и методах
распределения (классификации) организмов в
иерархическом плане.
11. Таксономические категории
Высшие таксоныНизшие таксоны
царство
морфовар
отдел
хемовар
класс
биовар
порядок
патовар
семейство
серовар
род
фаговар
вид
12.
• Основной таксономической единицей вбиологии является вид (species). Вид – это
эволюционно сложившаяся совокупность
микроорганизмов, имеющих единое
происхождение, сходный генотип и
максимально близкие фенотипические
признаки и свойства.
13. Принципы систематики:
•Филогенетический (для крупных таксонов).• Фенотипический. В нем используются:
◊ тинкториальные свойства — способность окрашиваться
различными красителями;
◊ культуральные свойства — особенности роста бактерий на
жидких и плотных питательных средах;
◊ подвижность;
◊ спорообразование — форма и характер расположения споры в
клетке;
◊ физиологические свойства — тип питания, тип дыхания; ◊
биохимические свойства — способность ферментировать
различные субстраты;
◊ антигенные свойства.
14.
• Генотипический. Для классификациибактерий, помимо изучения их
фенотипических свойств, все более
широко используют методы
геносистематики. В ее основе лежит
изучение нуклеотидного состава ДНК и
наиболее важных характеристик
генома, в частности, его размера
(величина, объем, молекулярная
масса) и других параметров. Наиболее
точным методом установления
генетического (геномного) родства
между бактериями является
определение степени гомологии ДНК.
Чем больше идентичных генов, тем
выше степень гомологии ДНК и ближе
генетическое родство.
15.
• Смешанный(нумерический). В основе
нумерической таксономии
лежит принцип
сопоставления организмов
по возможно большему
количеству учитываемых
признаков при допущении,
что все они для систематики
равноценны. Однако
принцип равнозначности
является основным
недостатком этого метода.
16. Классификация микроорганизмов
• Классифицировать обитателей микромираможно по разным признакам. Дальше
будут приведены несколько классификаций.
• В основу классификации микробов
положены морфологические,
физиологические, биохимические и
молекулярно-биологические свойства.
17.
18. I. По наличию клеточной структуры:
• 1. Микробы – все живые формы микромираклеточные и доклеточные (включая вирусы,
прионы, вироиды)
• 2. Микроорганизмы – микробы, имеющие
клеточное строение (это только бактерии
(например: кишечная палочка), грибы
(например: кандида), простейшие
(например: дизентерийная амеба)).
19. II. По патогенности (способности вызывать инфекционные заболевания):
• 1. Патогенные – микробы, вызывающиеинфекционное заболевание
• 2. Непатогенные – микробы, не вызывающие
инфекционное заболевание 3. Условнопатогенные – микробы, которые могут вызвать
инфекционное заболевание при определенных
условиях.
• Таким образом, медицинская микробиология
занимается изучением строения и
жизнедеятельности патогенных и условнопатогенных для человека микробов.
20. Классификация бактерий по типам дыхания:
1. Облигатные аэробы (возбудители туберкулеза, чумы, холеры) –
микроорганизмы, для оптимального роста которых необходим кислород.
2. Облигатные анаэробы (возбудители столбняка, ботулизма, газовой
анаэробной инфекции, бактероиды, фузобактерии) – бактерии, которые растут
при отсутствии кислорода за счет процессов брожения. Они получают
кислород из органических соединений в процессе их метаболизма. Некоторые
из них не выносят даже незначительного количества свободного кислорода.
3. Факультативные анаэробы (стафилококки, ешерихии, сальмонели, шигели и
другие) – могут расти и размножаться как в присутствии кислорода, так и без
него..
4. Микроаэрофилы (молочнокислые, азотфиксирующие бактерии) – особенная
группа микробов, для которых концентрация кислорода при культивировании
может быть уменьшена до 2 %. Высшие его концентрации способны
задерживать рост.
5. Капнеические (возбудитель бруцеллеза бычьего типа) – микроорганизмы,
которые требуют, кроме кислорода, еще и до 10 % углекислого газа.
21. Классификация бактерий по типам питания:
1. Автотрофы
2. Гетеротрофы
А. Паразиты
Б. Сапрофиты Важнейшим химическим элементом, необходимым клетке,
является углерод. В зависимости от источника его получения бактерии
делятся на два типа – автотрофы и гетеротрофы. Автотрофы способны
усваивать его из углекислого газа. Синтез белков, жиров и углеводов
происходит на основе неорганических элементов. К этой группе, в частности,
относятся многие почвенные микробы и цианобактерии.
Автотрофы – это первичные производители органики, и они являются
начальным звеном многих цепочек питания. Гетеротрофы получают углерод
из готовых органических соединений. Среди них выделяют паразитов и
сапрофитов. Паразиты питаются органическими веществами,
произведенными другими живыми существами. Сапрофиты – это микробы
гниения, разлагающие мертвую органику. Большая их часть относится к
почвенным бактериям .
22. Морфология бактерий.
• Форма и размеры бактерий. Основные формы бактерий– шаровидная, палочковидная и извитая.
• Шаровидные бактерии – кокки имеют обычную
форму шара, встречаются также уплощенные,
слабоовальной или бобовидной формы. Кокки могут
быть в виде: одиночных клеток – монококки
(микрококки); клеток, соединенных в различных
сочетаниях: попарно – диплококки; соединенных по
четыре клетки – тетракокки; более или менее длинных
цепочек – стрептококки; скоплений кубической формы
(в виде пакетов) из восьми клеток, расположенных в два
яруса один над другим, – сарцины; скоплений
неправильной формы, напоминающих грозди
винограда, – стафилококки.
23.
24.
• Палочковидные бактерии могут быть:одиночными; соединенными попарно –
диплобактерии; цепочками по три-четыре и более
клеток – стрептобактерии. Соотношения между
длиной и толщиной палочек бывают самыми
различными. Извитые, или изогнутые, бактерии
различаются длиной, толщиной и степенью
изогнутости. Палочки, слегка изогнутые в виде
запятой, называют вибрионами, палочки с одним
или несколькими завитками в виде штопора –
спириллами, а тонкие палочки с многочисленными
завитками – спирохетами.
25. Ультраструктура бактериальной клетки.
• Клетка прокариотных организмов, к которым относятсябактерии, обладает принципиальными особенностями
ультраструктуры. На рис. представлена схема строения
бактериальной клетки. Клеточная стенка (оболочка) –
важный структурный элемент большинства бактерий.
На долю клеточной стенки приходится от 5 до 20%
сухих веществ клетки. Она обладает эластичностью,
служит механическим барьером между протопластом и
окружающей средой, придает клетке определенную
форму. В состав клеточной стенки входит
специфическое для прокариотных клеток
гетерополимерное соединение – пептидогликан
(муреин), отсутствующий в клеточных стенках
эукариотных организмов.
26.
27.
• По методу окраски, предложенному датским физиком X. Грамом (1884г.), бактерии делятся на две группы: грамположительные и
грамотрицательные . Грамположительные клетки удерживают краску,
а грамотрицательные не удерживают ее, что обусловлено различиями
в химическом составе и ультраструктуре их клеточных 17 стенок. У
грамположительных бактерий клеточные стенки более толстые,
аморфные, в них содержится большое количество муреина (от 50 до
90% сухой массы клеточной стенки) и тейхоевые кислоты. Клеточные
стенки грамотрицательных бактерий более тонкие, слоистые, в них
содержится много липидов, мало муреина (5-10%) и отсутствуют
тейхоевые кислоты. В последнее время установлено, что разделение
на «грамположительные» и «грамотрицательные» теряет свое
значение в связи с тем, что некоторые грамположительные бактерии
быстро теряют способность удерживать в клеточной стенке комплекс
йода с красителем после прекращения активного роста, например,
бактерии рода Bacillus.

Биология
Биология








